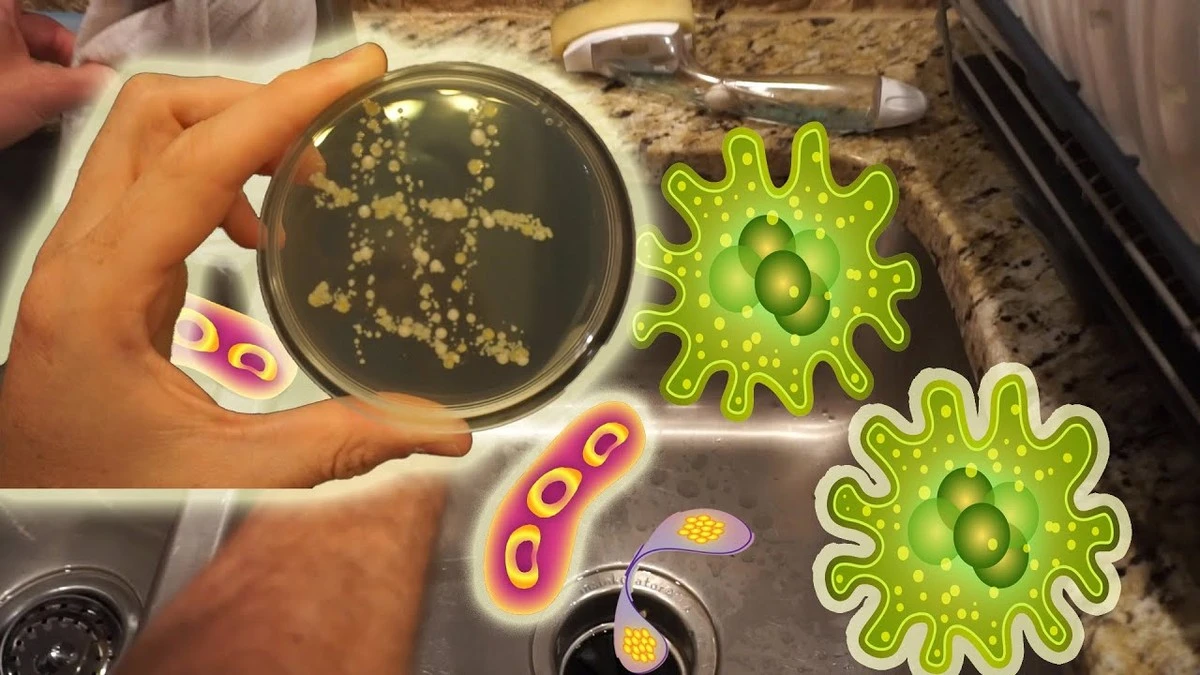
dlaczegonigdyni-extra-1.webp Dlaczego nigdy nie powinieneś myć talerzy w zlewie bez jego wcześniejszego szorowania - image 1

Większość z nas wierzy, że góra piany i zapach cytryny to gwarancja sterylnej czystości. W polskich domach, gdzie tradycja ręcznego zmywania jest wciąż silna, często ulegamy złudzeniu optycznemu. Twoje naczynia mogą lśnić, ale biologicznie wciąż mogą być siedliskiem bakterii.
Problem nie leży w płynie do naczyń, ale w miejscu, które uznajemy za "strefę czystości". Jeśli nie zmienisz jednej prostej nawykowej czynności, Twoje wysiłki przy zlewie mogą przynieść więcej szkody niż pożytku.
Zlew bywa brudniejszy niż deska klozetowa
W mojej praktyce domowej często zauważałem, że traktujemy zlew jako narzędzie do czyszczenia, zapominając, że sam wymaga dezynfekcji. To właśnie tutaj lądują resztki surowego mięsa, osady z kawy i tłuszcz. Kładzenie talerzy bezpośrednio w nieumytym zlewie sprawia, że fundujesz im "kąpiel" w mikroskopijnym koktajlu bakterii.
Ale to nie jedyny błąd. Wielu Polaków wciąż myje naczynia w stojącej wodzie, aby zaoszczędzić na rachunkach. Bez dokładnego płukania pod bieżącym strumieniem, na widelcach zostają resztki detergentu i niewidoczny gołym okiem brud.
Jak uzyskać prawdziwą sterylność bez zmywarki?
Prawdziwa higiena nie zaczyna się od talerza, ale od przygotowania stanowiska pracy. Oto jak robią to profesjonaliści:
- Krok zero: Przed myciem naczyń wyszoruj zlew i ociekacz gorącą wodą z octem lub środkiem odkażającym.
- Zasada 45 stopni: Woda powinna mieć temperaturę około 45°C. To wystarczy, by rozpuścić tłuszcz, ale oszczędzi Twoje dłonie (używaj rękawic!).
- Strategiczna kolejność: Zacznij od szklanek, potem umyj sztućce i talerze. Garnki i tłuste patelnie zostaw na sam koniec, by nie zanieczyścić gąbki na samym starcie.
Pamiętaj o najważniejszym: gąbka kuchenna to największy wróg czystości, jeśli używasz jej dłużej niż tydzień. Kupowanie wielopaków w popularnych dyskontach i częsta wymiana to najtańsza polisa zdrowotna dla Twojej rodziny.
Mały trik dla nieufnych
Jeśli chcesz mieć pewność, że Twoje naczynia są bezpieczne, po myciu pozwól im wyschnąć naturalnie na czystym ociekaczu w przewiewnym miejscu. Wycieranie ich starą, wilgotną ściereczką to najprostszy sposób, by z powrotem przenieść na nie drobnoustroje.
A Ty jak często wymieniasz gąbkę w swojej kuchni – czekasz, aż zmieni kolor, czy robisz to profilaktycznie co kilka dni?









